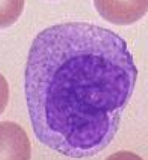
<p>What blood cell is this?</p>
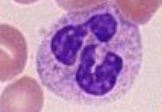
<p>What blood cell is this?</p>
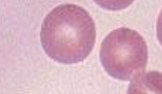
<p>What blood cell is this?</p>

A&P Practical #2
1/55
There's no tags or description
Looks like no tags are added yet.
Name | Mastery | Learn | Test | Matching | Spaced | Call with Kai |
|---|
No analytics yet
Send a link to your students to track their progress
56 Terms
What vessels have valves?
vein and lymph
How many permanet teeth do we have?
32
how many deciduos teeth do we have?
20
What are our baby/premature teeth called?
Deciduos
What is the largest artery in the body?
aorta

What blood cell is this?
lymphocyte
What blood cell is this?
monocyte
What blood cell is this?
neutrophil

What red blood cell is this?
platelet erythrocyte
What blood cell is this?
red blood cell

What blood type is this?
AB type

What blood type is this?
Type A

What blood type is this?
Type B

What blood type is this?
Type O

What is the red highlight?
right auricle

What is the blue highlight?
left auricle

What is highlighted yellow?
Superior vena cava

What is highlighted in the green?
aorta

What is highlighted in the pink?
pulmonary trunk

What is highlighted in pink?
right atrium

What is the end of the pink highlight called?
left pulmonary artery

what is highlighted in yellow?
tricuspid valve

What is highlighted in green?
chordae tendineae

What is highlighted in red?
right ventricle

What is highlighted in pink? (located at the end of the cordae tendineae)
capillary muscle

What is highlighted in the green?
interventricular septum

what is highlighted in light blue?
left atrium

What is highlighted in red?
bicuspid valve

What is highlighted in dark blue ( located in the left ventricle and slightly under the pulmonary trunk)?
the aortic valve

What is not highlighted in this image?
left ventricle

What is located under the pulmonary trunk?
pulmonary valve
what is the outer layer of the heart called?
epicardium
what is the middle layer of the heart?
myocardium
what is the inner layer of the heart called?
endocardium

What is the main artery in the middle?
anterior interventricular artery

What is the artery on the right called?
right coronary artery

Which one is the vein?
the right (smaller/thinner)

Which one is the artery?
the left one (larger)
What is the inside/open space of the vein/artery called?
lumen

What layer of the vein/artery is highlighted in orange?
tunica intima

What layer of an artery/vein is highlighted in green?
tunica media

what layer of an artery/vein is highlighted in blue?
tunica externa

What is highlighted in the blue/ is blue?
jugular vein

What is highlighted in yellow?
common carotid artery

what is highlighted in green?
Brachiocephalic artery

What is the pink highlight?
subclavian artery and veins

What is highlighted in green?
axillary artery

What is outlined in yellow?
brachial artery

What is outlined in black?
radial artery

what is outlined in blue?
ulnar artery

What is circled in black?
vertebral artery
what artery do you use to take blood pressure?
brachial artery

What is highlighted in teal?
hepatic artery

What is highlighted in yellow?
renal arteries

What is highlighted in green?
inferior ven cava

what is highlighted in blue
abdominal aorta